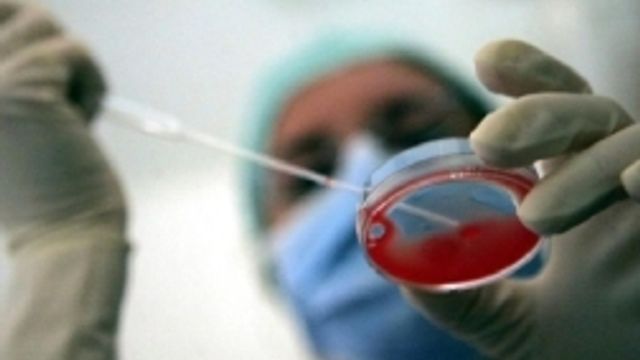

Il Ministero della Salute assicura che in Italia non c'è nessun caso di infezione causata dal nuovo Coronavirus, e conferma che l'Organizzazione Mondiale della Sanità, pur consigliando alle autorità sanitarie la massima attenzione, non ha rilevato una situazione di particolare allarme e non consiglia misure di restrizione ai viaggi all'estero. In Italia è attiva una rete di sorveglianza delle gravi infezioni e sindromi respiratorie (SARI e ARDS).
Continua a leggere su tgcom24